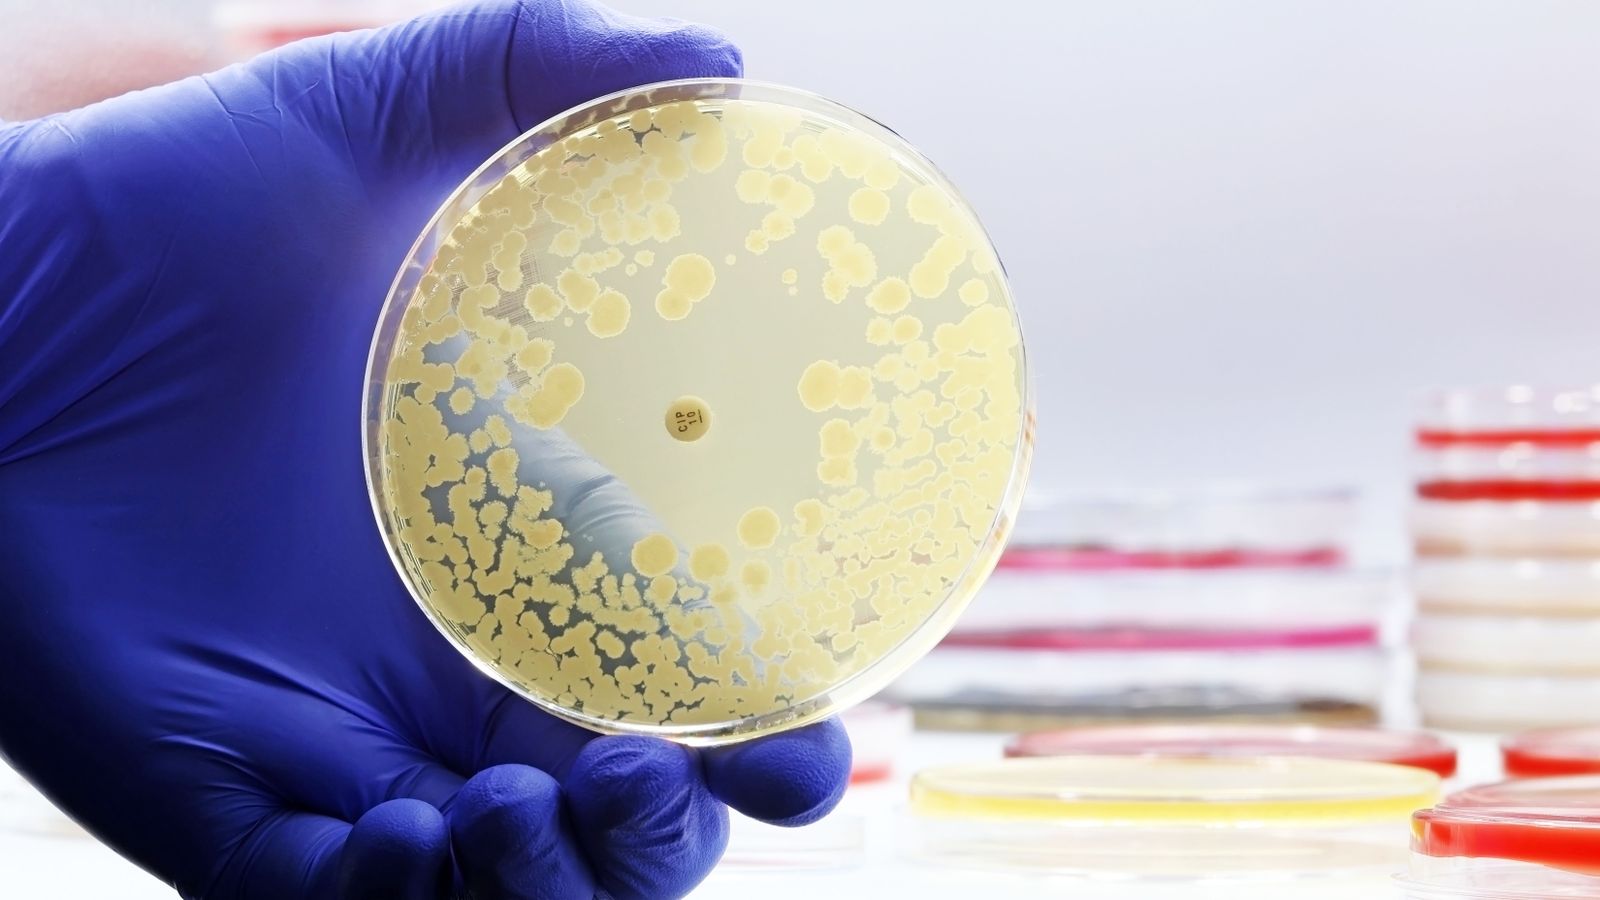
Cultiu microbiològic en una placa de Petri (arxiu)

Els superbacteris poden provocar més de 39 milions de morts en els pròxims 25 anys
Un estudi de The Lancet estima el potencial impacte de la resistència dels microbis als antibiòtics en la sanitat global
Més d'un milió i mig de persones moriran cada any en tot el món per infeccions derivades de resistència als antibiòtics, que ocorren quan els bacteris o altres patògens canvien de manera que evolucionen fins a deixar de respondre a estos fàrmacs. És la conclusió d'una anàlisi a escala global difosa este dilluns per la prestigiosa revista The Lancet, que estima que al llarg dels pròxims 25 anys s'hauran produït més de 39 milions de decessos per este motiu.
L'estudi aborda en profunditat els efectes en la sanitat global de la resistència antimicrobiana (RAM) al llarg del temps, un fenomen agreujat per l'ús excessiu o indegut que fa la població dels antibiòtics i sobre el qual ja han alertat entitats com ara l'Organització Mundial de la Salut (OMS). En este context, la nova investigació examina les tendències registrades entre el 1990 i el 2021 i estima l'impacte potencial entre el moment present i l'any 2050 per a 204 països i territoris.
Segons l'anàlisi de The Lancet, més d'un milió de persones van morir de RAM en tot el món durant el període abordat. Els decessos entre menors de cinc anys per esta causa van decaure en un 50% mentre que, en canvi, les morts de persones majors de 70 anys van augmentar més d'un 80%. La recerca indica que prediccions futures apunten al fet que les morts per este motiu augmentaran en les pròximes dècades i s'incrementaran quasi un 70% el 2050 enfront del 2022. El col·lectiu poblacional més colpejat serà la tercera edat.
També se'n desprén que un accés més gran a l'atenció sanitària i els antibiòtics podrien salvar un total de 92 milions de vides entre el 2025 i el 2050. Les troballes subratllen igualment la necessitat d'adoptar mesures decisives com una millor atenció sanitària, més prevenció i mesures de control i nous antibiòtics per a protegir les persones de l'amenaça de la RAM.
En xifres concretes, l'estudi estima que 1,91 milions de persones podrien potencialment morir com a resultat directe de la resistència als antimicrobians el 2050, quasi un 70% més que el 2022. Durant el mateix període, el nombre de morts en què els superbacteris exerceixen un paper decisiu augmentarà quasi un 75%. Així doncs, ascendirà de 4,71 milions a 8,22 milions cada any.
Estes tendències s'accentuaran, segons les dades, les pròximes dècades i posen de manifest la vital necessitat d'efectuar intervencions com ara prevenció d'infeccions, vacunes i minimitzar l'ús inadequat dels antibiòtics.
L'autor de l'anàlisi és Mohsen Naghavi, líder de l'equip d'investigació de RAM en Institut de Mètriques de Salut (IHME) de la Universitat de Washington, als Estats Units. Afirma que "les medicines antimicrobianes són una de les pedres angulars de la sanitat moderna i el fet d'incrementar-hi la resistència és molt preocupant". "Estes troballes posen en relleu que les RAM han sigut una significativa amenaça per a la sanitat global durant dècades i que estan augmentant", afegeix l'expert.
L'estudi també remarca que observar com les tendències en les morts per RMA han canviat al llarg del temps i com variaran probablement en el futur és "vital per a prendre decisions informades per a ajudar a salvar vides".


